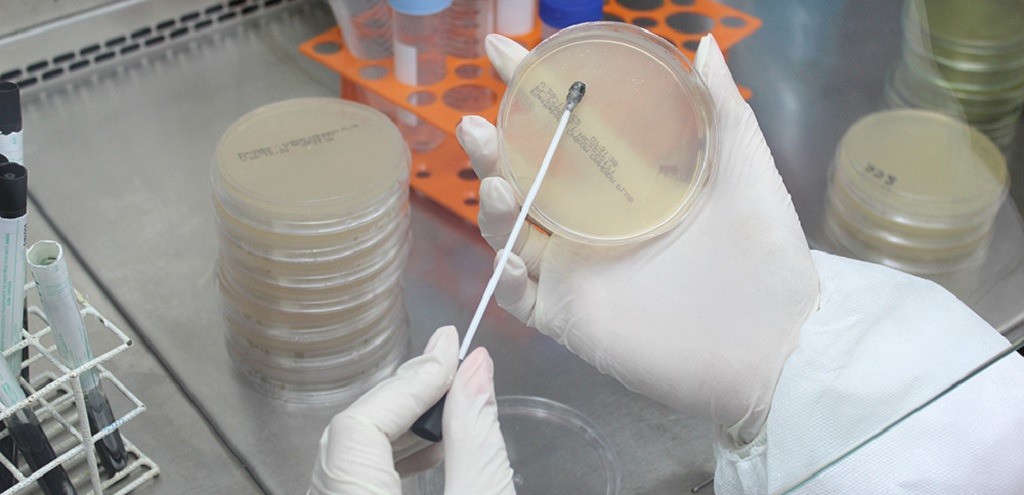

HU-FURG INICIA CICLO DE APLICAÇÃO DO IMUNIZANTE PALIVIZUMABE
Pelo quinto ano seguido, o Hospital Universitário Dr. Miguel Riet Corrêa Jr., da Universidade Federal do Rio Grande (HU-Furg), vinculado à Empresa Brasileira de Serviços Hospitalares (Ebserh), realiza a aplicação do Palivizumabe, imunizante contra o Vírus Sincicial Respiratório (VSR), um dos agentes causadores da bronquiolite. Nesta sexta-feira (24), 26 pacientes começaram o ciclo 2023 de imunização, que pode chegar a cinco doses anuais (por criança).
Se antes os pacientes eram encaminhados para Pelotas, distante aproximadamente 60km de Rio Grande, desde 2019, quando o HU-Furg passou a ser polo regional, os usuários recebem as doses mais próximo de casa. Os municípios atendidos são Rio Grande, São José do Norte, Chuí, Santa Vitória do Palmar e outros. Os dados da Secretaria Estadual de Saúde (SES) mostram que em 2019, foram beneficiados 28 pacientes. Já em 2020, no início da pandemia de Covid-19, foram 21; no ano seguinte, 22 pacientes receberam o imunizante; e em 2022, foram atendidos 33 pacientes.
Os principais desafios impostos pela Covid-19 para a aplicação do Palivizumabe, segundo a pediatra Marilice Magroski, foram a organização do espaço no Hospital Universitário e o estabelecimento de um fluxo que evitasse a concentração de muitos pacientes na sala de espera, bem como o transporte das crianças até o HU, já que algumas vinham de outras cidades. “É muito positivo o balanço das imunizações realizadas de 2019 a 2022, pois foram poucas internações por bronquiolite dentro do grupo de pacientes atendidos. Quando ocorreram, foram de pouca gravidade e não tivemos óbitos pela doença”, pontuou a especialista.
Ainda de acordo com a pediatra, para receber a imunização, é necessário que a criança se enquadre nos seguintes critérios estabelecidos pela portaria conjunta SAS-SCTIE/MS n° 23, de 23/10/2018:
- Ser menor de um ano de idade (até 11 meses e 29 dias), tendo nascido prematura com idade gestacional menor ou igual a 28 semanas (28 semanas e 6 dias);
- Menor de dois anos, com doença pulmonar crônica da prematuridade (DPCP), definida pela dependência de oxigênio em prematuros a partir de 28 dias de vida, acompanhada de alterações típicas na radiografia pulmonar ou dependência de oxigênio com 36 semanas de idade gestacional corrigida, em prematuro extremo;
- Menor de dois anos de idade, com cardiopatia congênita com repercussão hemodinâmica demonstrada e hipertensão pulmonar grave ou em tratamento para insuficiência cardíaca congestiva (ICC).
A médica acrescentou que são incluídas as crianças com hipertensão pulmonar de moderada a severa, com cardiopatias cianóticas em uso de medicamentos para controlar insuficiência cardíaca congestiva e que precisarão de procedimento cirúrgico.
Método
Para a aplicação deste ano, o HU-Furg realizou o levantamento de pacientes nascidos e/ou atendidos no HU-Furg que se enquadrassem nos critérios, bem como consultou a comunidade médica local para buscar elegíveis fora do Hospital. Depois de reunida a equipe multiprofissional, foram definidas as datas de aplicação e divididas as tarefas. Além disso, foi organizado o fluxo de atendimento, que começa com a solicitação e a entrega de documentos, segue com avaliação, autorização e cadastro do paciente no sistema do Ministério da Saúde (MS) para, por fim, chamar as crianças que se enquadram nos critérios para o recebimento do imunizante.
Um pequeno guerreiro mais forte e confiante
Nascido num quadro de prematuridade extrema, com 27 semanas e cinco dias, pesando pouco mais de 1kg e tendo 36cm, Gabriel Chaves precisou de suporte ventilatório por muitas semanas, tornando-o mais propício a desenvolver doenças respiratórias. Essa condição de prematuridade extrema enquadrou Gabriel nos critérios para a imunização com o Palivizumabe.
Já em casa, os pais viviam com medo constante de adoecimento por outras patologias e, assim, procuraram oferecer um ambiente com temperatura controlada, acesso restrito e saídas controladas, de modo que fosse similar à UTI Neonatal. Após a imunização e mais protegida, a criança não precisou voltar para o hospital e não apresentou mais problemas respiratórios, desde os simples até os mais graves.
“Agora, com quase dois anos, Gabriel tem uma vida normal, interagindo com outras crianças e adultos, além de frequentar todos os ambientes que frequentamos, sendo uma criança extremamente saudável, inteligente e com um ótimo desenvolvimento”, comentou a mãe, Cintia Passos.
Gabriel foi imunizado nos ciclos de 2021 e 2022, sua mãe agradeceu a equipe por toda a dedicação, orientação e busca ativa dos pacientes que devem ser imunizados. “Eu e meu marido somos eternamente gratos a toda a equipe do HU-Furg pela responsabilidade dos profissionais e todo o acolhimento dedicado a nós, em cada dose aplicada! Cada vez que o Gabriel ia fazer o imunizante era um alívio para os nossos corações, em saber que ele estava mais protegido, mais saudável e mais perto de ter uma vida com menos restrições e, com isso, menores chances de hospitalização”, disse.
Assessoria de comunicação HU-Furg
Assessoria